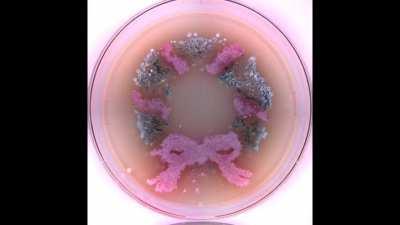
Since you liked the Christmas tree so much, here's a wreath!

labrats
labrats

Browse Other Categories
- albanophobia
- Altrive
- AmazighPeople
- Aniela_Leon_
- apexmemes
- ArianeSaintAmourFans
- CARTOON
- CODM_GUNSMITH
- cozy
- CrustalLustONLF
- emocringe
- fnfrecharts
- funnyvideostills
- GiadaDeLaurentiis
- Huawei
- Jazzymejia
- Lavendamonroe
- monkeescirclejerk
- polydactyl
- SansMemes
- tankiejerkbutbased
- telaviv
- Titanfall_2_
- u_jake0320
- worldofgothic

![[OC] Agarose gel tutorial](https://img.reddit.tube/thumbnails/3439625fb7aad780ad1e3666ec409d639781daeb.jpg?v=19700101120000)


